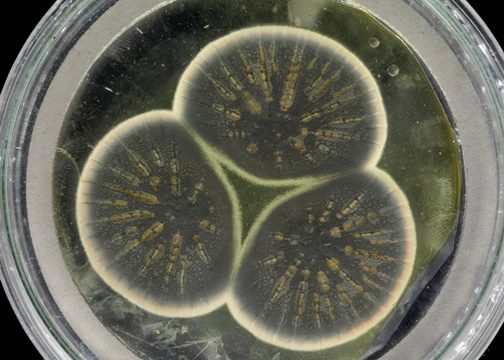

|
| Foto: Daniela Vasconcelos/TV Globo |
Por G1 SP e TV Globo — A primeira-dama Michelle Bolsonaro, mulher do presidente Jair Bolsonaro (sem partido), foi ouvida na tarde desta quinta-feira (24) na Delegacia de Crimes Eletrônicos do Departamento Estadual de Investigações Criminais (DEIC) em São Paulo, em inquérito que investiga ofensas sofridas por ela pela internet.
O registro da queixa da primeira-dama foi marcado para as 15h30, quando ela foi atendida pelo delegado Carlos Ruiz, especializado em crimes cibernéticos.
Michelle Bolsonaro ficou cerca de 10 minutos no prédio do Deic, na Zona Norte de São Paulo, e deixou o local sem fazer declarações à imprensa.
Segundo a polícia, a defesa de Michelle fez um requerimento para que sejam investigadas ofensas recebidas por ela na internet, que podem configurar crime contra a honra. Nesses casos, a própria vítima precisa ir pessoalmente dizer ao delegado que quer iniciar uma investigação.
Ao ir ao Deic nesta quinta-feira (24), a primeira-dama autorizou o delegado a abrir o inquérito para investigar as ofensas contra ela.
De acordo com os investigadores, o caso será assumido pela 4ª Divisão de Investigações Gerais do DEIC, na delegacia de crimes cometidos por meios eletrônicos, liderada pelo próprio delegado Carlos Ruiz.
A investigação será feita em São Paulo porque o provedor de internet de onde partiram as ofensas contra a primeira-dama fica no estado.
Rachadinha
A primeira-dama Michelle Bolsonaro também é alvo de uma investigação que apura o repasse de R$89 mil que o ex-assessor Fabrício Queiroz e a mulher dele, Márcia Aguiar, depositaram em cheques na conta bancária dela. Os depósitos de Queiroz foram revelados pela revista “Crusoé”.
O nome da primeira-dama apareceu nas investigações pela primeira vez em dezembro de 2018. Quando o relatório do Coaf identificou as movimentações suspeitas na conta do ex-assessor de Flávio Bolsonaro, mostrou que Fabrício Queiroz tinha feito depósitos em cheque para Michelle Bolsonaro, que somaram R$ 24 mil.
Na época, o presidente Jair Bolsonaro justificou as transferências. Disse que havia emprestado dinheiro a Queiroz e que os depósitos na conta da mulher eram parte do pagamento dessa dívida: “Não foi por uma, foi por duas vezes que o Queiroz teve dívida comigo e me pagou com cheques. E não veio para a minha conta esse cheque, porque simplesmente eu deixei no Rio de Janeiro. Não estaria na minha conta. E não foram R$ 24 mil; foi R$ 40 mil”.
Mas as movimentações financeiras do ex-assessor Fabricio Queiroz, divulgadas pela revista “Crusoé”, revelam que os depósitos em cheque na conta de Michelle Bolsonaro somam um valor maior: R$ 72 mil.
Segundo a reportagem, os extratos mostram que a conta da primeira-dama começou a ser abastecida por Queiroz em 2011. Ele depositou pelo menos 21 cheques para Michelle Bolsonaro. Foram três cheques de R$ 3 mil em 2011; seis também de R$ 3 mil em 2012; e mais três cheques de novo de R$ 3 mil em 2013. Em 2016, há registros de nove depósitos que somam R$ 36 mil.
A revista afirma que em todos os extratos bancários de Fabricio Queiroz não constam depósitos de Jair Bolsonaro para a conta do ex-assessor. Nem mesmo os R$ 40 mil que o presidente afirmou ter emprestado a Queiroz.
O Ministério Público afirma que Queiroz era o operador financeiro do suposto esquema da rachadinha no gabinete do filho do presidente na Assembleia Legislativa do Rio, quando Flávio Bolsonaro era deputado estadual. No esquema, o parlamentar fica com parte do salário dos assessores.
O MP aponta Flávio Bolsonaro como o líder de uma organização criminosa e diz que Queiroz seria responsável por receber o dinheiro de outros assessores e fazer pagamentos para cobrir despesas do chefe.
A revista apurou que, entre 2007 e 2018, os créditos na conta de Fabricio Queiroz somaram R$ 6,2 milhões. Desse total, R$ 1,6 milhão são identificados como salários que ele recebeu como policial militar e assessor na Assembleia Legislativa. Outros R$ 2 milhões vieram de 483 depósitos de servidores do gabinete de Flávio Bolsonaro. Há ainda R$ 900 mil em créditos, em dinheiro, sem a identificação de quem depositou.
Fabrício Queiroz e a esposa repassaram R$ 89 mil para Michelle Bolsonaro
Fabricio Queiroz foi preso no dia 18 de junho em Atibaia, no interior de São Paulo, na casa do então advogado da família Bolsonaro. 22 dias depois, Queiroz e a mulher dele, Márcia Aguiar – que estava foragida da Justiça – ganharam o direito de cumprir prisão domiciliar. Com tornozeleira eletrônica, os dois não podem ir além da varanda do apartamento na Zona Oeste do Rio.
O Jornal Nacional, da TV Globo, confirmou as informações da revista, mas apurou que os repasses de dinheiro para Michelle Bolsonaro são ainda maiores e não foram feitos apenas por Fabricio Queiroz. A mulher do ex-assessor de Flávio também fez depósitos para a primeira-dama.
Márcia Aguiar repassou R$ 17 mil para Michelle Bolsonaro de janeiro a junho de 2011. Os depósitos foram feitos em cinco cheques de R$ 3 mil e um de R$ 2 mil. No total, Queiroz e a mulher dele repassaram R$ 89 mil para a primeira-dama.
Na ocasião da denúncia, o Palácio do Planalto não se pronunciou sobre o caso.
A defesa de Fabrício Queiroz e Márcia Aguiar afirmou que só vai se manifestar sobre eventuais informações de caráter sigiloso nos autos.





 Jair Bolsonaro
Jair Bolsonaro